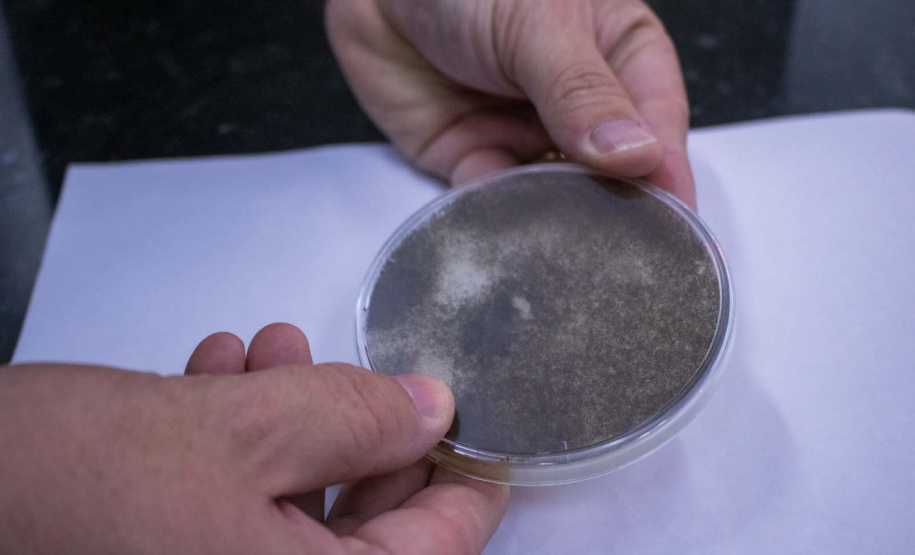
Apoiada pelo Estado, startup paranaense transforma  fungos em “carne”

Um hambúrguer sem carne com o mesmo sabor da carne, menos gordura e calorias e mais proteína e fibras. Essa é a proposta da Typcal, spin-off da startup Fungi Biotecnologia, que tem sedes em Curitiba e Ponta Grossa. A foodtech paranaense inovou ao desenvolver uma proteína concentrada no micélio, que é a parte vegetativa de fungos e cogumelos. A startup foi umas das 68 selecionadas no primeiro edital do Paraná Anjo Inovador e recebeu R$ 250 mil de incentivo do programa desenvolvido pelo Governo do Estado, por meio da Secretaria da Inovação, Modernização e Transformação Digital.
A ideia surgiu em 2021 quando o engenheiro de bioprocessos Eduardo Sydney juntou forças com o empreendedor da indústria de alimentos Paulo Ibri para criar um alimento alto em proteínas e fibras, e baixo em gordura e calorias. Diretor de Tecnologia da startup, ele explica que uma das maiores dificuldades de alimentos à base de plantas, como soja e ervilha, é o sabor.
“A vantagem do micélio é que ele não tem sabor nenhum, então quando você adiciona como ingredientes não afeta o sabor do produto. Nossa expectativa é escalar a produção e ver os primeiros produtos a base de micélio no mercado já em 2025”, afirma o engenheiro de produção.
O ingrediente é produzido a partir de um processo de fermentação líquida semelhante ao utilizado na produção de cervejas e etanol. O produto final sólido tem características como textura e aparência similares a um frango desfiado, sabor neutro, além de benefícios à saúde. Dessa forma ele pode ser usado no mercado vegano e vegetariano como um substituto de frango, por exemplo.
- Seleção do Estado para vaga de diretor especialista em IA avança para última etapa
-
Governo abre inscrições para seminário sobre contratação de inovação pelo Setor Público
Outro foco da empresa é inserir o produto no mercado de comidas saudáveis, misturando a proteína do micélio com a proteína animal. Segundo Sydney, um hambúrguer híbrido contém 50% menos gordura e calorias, e maior quantidade de fibras, melhorando o perfil nutricional. Outra possibilidade é usar o ingrediente no mercado de nutrição esportiva para aumentar o valor nutricional de alimentos, como barrinhas de proteína, shakes e snacks.
Atualmente a empresa está em fase de escala piloto e de interação com a indústria, fechando os primeiros acordos comerciais para levar o produto para o mercado no próximo ano. Sydney explica que o aporte do Paraná Anjo Inovador é importante por causa da dificuldade de encontrar investidores no mercado na fase atual da startup.
“O investidor está focado na venda e geração de receita e não em desenvolver a tecnologia, que é uma área de risco, mas essencial para qualquer negócio, especialmente em biotecnologia. Por isso, o investimento do Governo do Paraná aumenta muito a nossa competitividade porque nos possibilita crescer como indústria, e no fim gerar empregos e renda para o próprio Estado”, afirma o diretor.
Além da Typcal, a tecnologia de fermentação do micélio ainda gerou outras duas spin-offs dentro da Fungi Biotecnologia. São elas a Mush, que trabalha com produção de embalagens e materiais sustentáveis e biodegradáveis, para os setores de arquitetura, designers e construção civil, como mesas, luminárias, peças de decoração e até urnas funerárias. E a Muush, que produz um biotecido similar ao couro que a indústria da moda aplica em bolsas, roupas, calçados e itens decorativos.
- Estado injeta R$ 17 milhões em 68 projetos inovadores no primeiro semestre
- Paraná Anjo Inovador divulga novas datas no cronograma da segunda edição
TECNOLOGIA – A Fungi atua com dois processos de fermentação: sólida e líquida. Em ambas são utilizados resíduos vegetais e subprodutos que sobram da agroindústria como palha, bagaço e folhas, para cultivar o fungo. Na produção dos alimentos da Typcal, a empresa usa o processo de fermentação líquida em que o fungo é adicionado em um meio líquido e ali ele se desenvolve dentro de um biorreator.
Essa técnica é pioneira na América Latina, sendo o processo fermentativo mais rápido do mundo quando comparado com outras startups que usam a mesma tecnologia. A média de tempo de fermentação de outras empresas é de 48h a 72h. A Typcal consegue realizar o mesmo processo em 24h, além de utilizar um fungo que tem histórico de consumo humano, o que facilita questões regulatórias para lançar o produto no mercado. Na escala atual, a fábrica-piloto consegue produzir até 100 quilos do micélio fresco por mês.
Segundo Sydney, no Brasil é necessário comprovar que a população já consome aquela espécie de fungo há mais de 25 anos, e que sem esse histórico seria preciso entrar com um novo ingrediente e passar por todas as etapas de regulação. “Cada startup trabalha com um tipo de fungo e nós escolhemos um que já é usado para a alimentação no Brasil. O que nos diferencia de outros players do mundo é o fungo que usamos e principalmente o tempo, porque conseguimos desenvolver um processo mais rápido e eficiente”, afirma.
A tecnologia desenvolvida pela Typcal também se destaca por ter uma produtividade 7 mil vezes maior e consumir 99% menos água que a de produção de carne bovina. Outro ponto é a redução de impactos ambientais e o alinhamento sustentável, uma vez que a empresa usa uma matéria-prima abundante e de baixo custo, os subprodutos da agroindústria que não são aproveitados pela indústria. Além disso, a produção acontece em escala vertical, utilizando menos espaço que uma fazenda de gado, por exemplo, que usa escala horizontal.